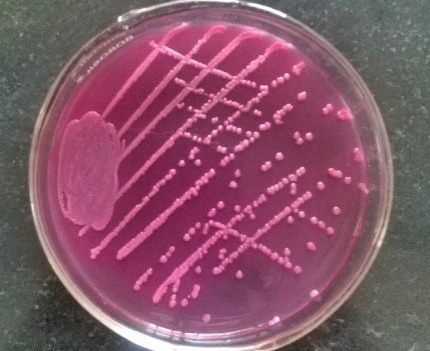

Advances in Animal and Veterinary Sciences
Research Article
Adv. Anim. Vet. Sci. 3 (5): 259 - 268
Figure1
Percentage sensitivity of E. coli isolates
Figure 2
Percentage sensitivity of Pseudomonas spp. isolates
Figure 3
Percentage sensitivity of Klebsiella spp. isolates
figure 5
Lacerated wound in horse
figure 6
Pink colonies over MLA
Figure 7
Fibro-sarcoma in Buffalo
Figure 4
Gun-shot wound in buffalo